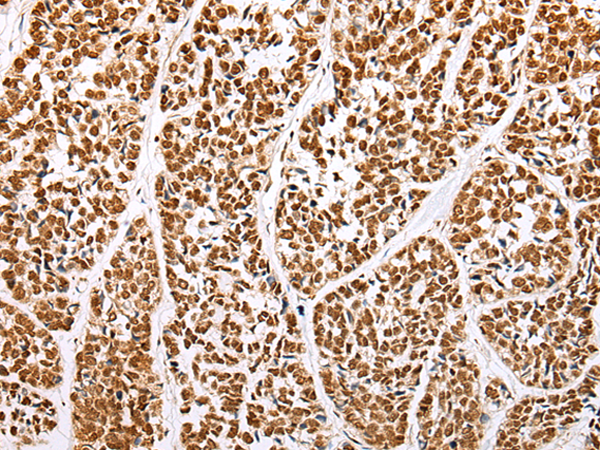

中文名稱: 兔抗ABCA1多克隆抗體
英文名稱: Anti-ABCA1 rabbit polyclonal antibody
別 名: ATP binding cassette subfamily A member 1; TGD; ABC1; CERP; ABC-1; HDLDT1
相關(guān)類別: 一抗
儲(chǔ) 存: 冷凍(-20℃)
宿 主: Rabbit
抗 原: ABCA1
反應(yīng)種屬: Human, Mouse
標(biāo) 記 物: Unconjugate
克隆類型: rabbit polyclonal
技術(shù)規(guī)格
|
Background: |
The membrane-associated protein encoded by this gene is a member of the superfamily of ATP-binding cassette (ABC) transporters. ABC proteins transport various molecules across extra- and intracellular membranes. ABC genes are divided into seven distinct subfamilies (ABC1, MDR/TAP, MRP, ALD, OABP, GCN20, White). This protein is a member of the ABC1 subfamily. Members of the ABC1 subfamily comprise the only major ABC subfamily found exclusively in multicellular eukaryotes. With cholesterol as its substrate, this protein functions as a cholesteral efflux pump in the cellular lipid removal pathway. Mutations in this gene have been associated with Tangier's disease and familial high-density lipoprotein deficiency. |
|
Applications: |
ELISA, WB, IHC |
|
Name of antibody: |
ABCA1 |
|
Immunogen: |
Synthetic peptide of human ABCA1 |
|
Full name: |
ATP binding cassette subfamily A member 1 |
|
Synonyms: |
TGD; ABC1; CERP; ABC-1; HDLDT1 |
|
SwissProt: |
O95477 |
|
ELISA Recommended dilution: |
5000-10000 |
|
IHC positive control: |
Human esophagus cancer |
|
IHC Recommend dilution: |
50-100 |
|
WB Predicted band size: |
254 kDa |
|
WB Positive control: |
Human bladder transitional cell carcinoma grade 2-3 tissue, Human bladder transitional cell carcinoma cancer next level 2-3 tissue lysates |
|
WB Recommended dilution: |
200-1000 |

購(gòu)物車
購(gòu)物車 幫助
幫助
 021-54845833/15800441009
021-54845833/15800441009
